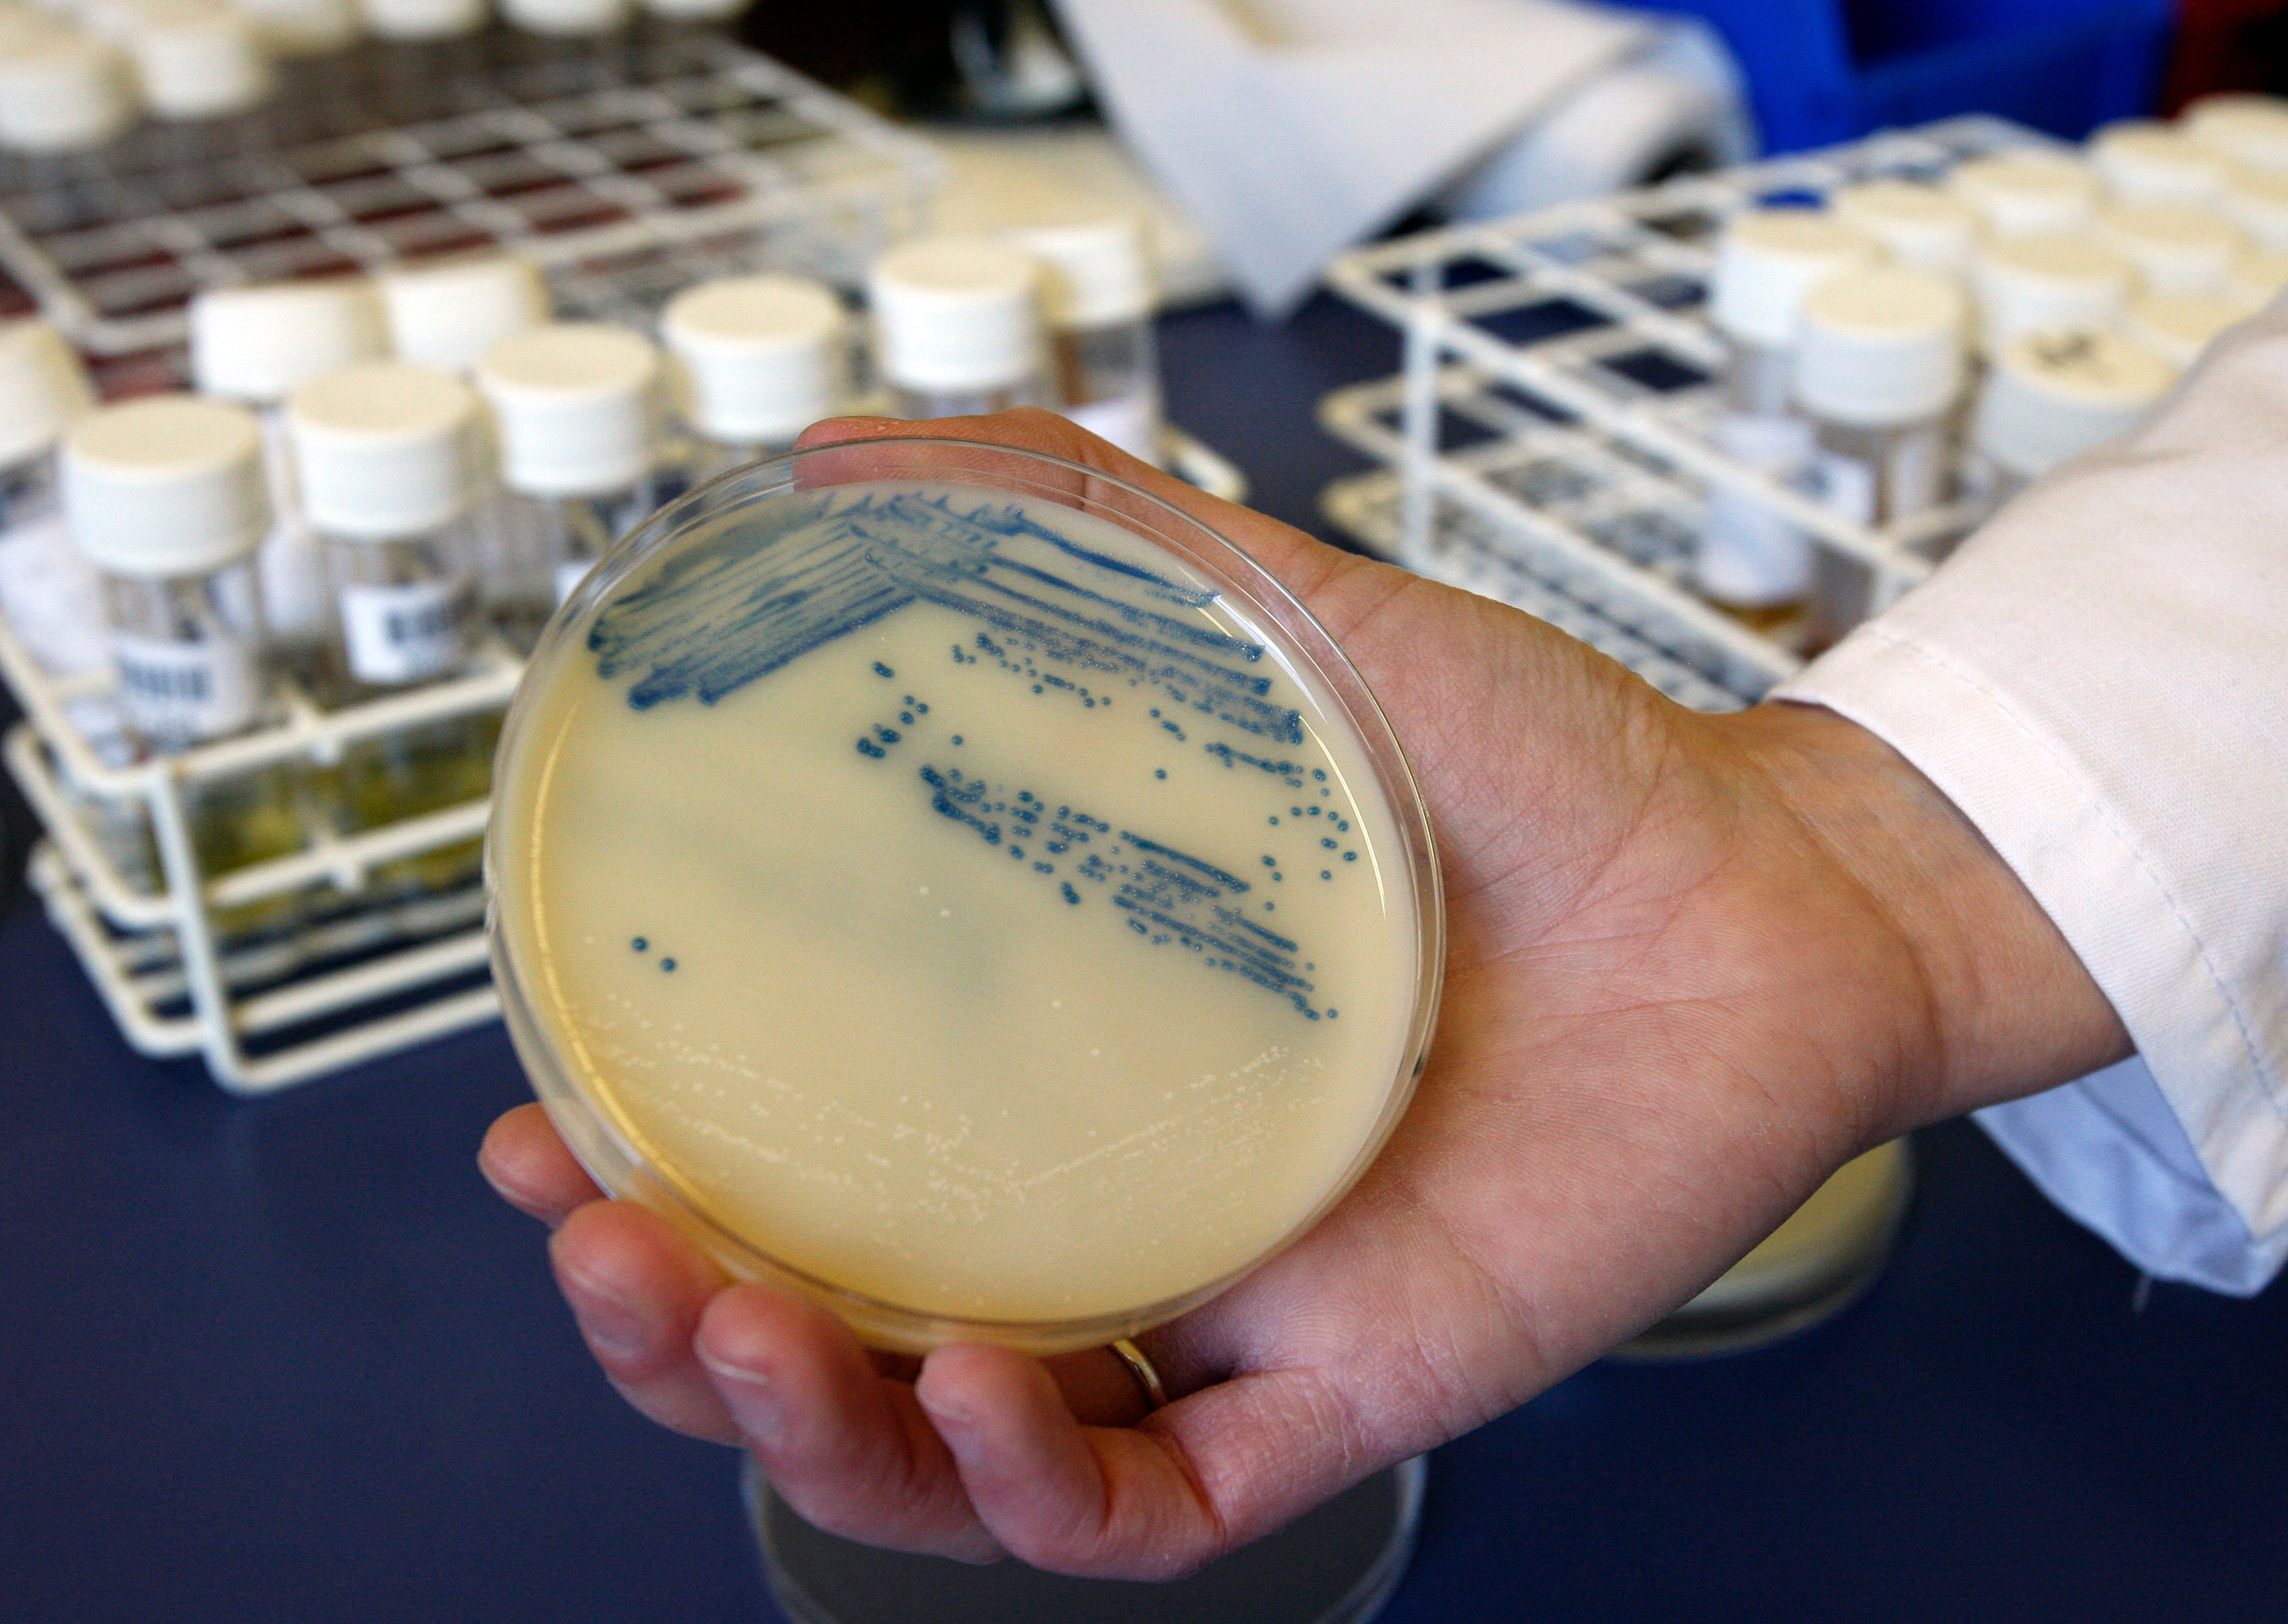
Superbug infections, deaths rose at beginning of pandemic

Top antibiotic expert nearly died from cut while gardening
Rick Bright ran antibacterial programs at the government’s US Biomedical Advanced Research and Development Authority

A top antibiotic expert says he nearly died after getting a life-threatening infection from a gardening cut.
Rick Bright says his health went downhill after he suffered “some sort of nick” on his thumb as he worked in his herb garden.
Mr Bright was at the time running antibacterial programs at the government’s US Biomedical Advanced Research and Development Authority.
He said that he finally took action following the 2018 incident after his infectious disease colleagues became concerned at the state of the cut.
“One of them looked at my thumb one day and said, ‘if you don’t get to the emergency room now, you could get sepsis and die,’” Mr Bright told Insider.
He said that he went to urgent care and was prescribed a cheap antibiotic, but that doctors had no idea what the issue was.
“I actually begged them and forced them to slice it open and culture it,” he said.
But his condition continued to worsen, and after multiple ER visits and prescriptions, lab results showed that he had a drug-resistant MRSA staph infection.
Mr Bright, who was hospitalised at this point, says that doctors were then able to give him a high-powered IV antibiotic, vancomycin, which does work against MRSA.
Rather than go into surgery the following day to have infected tissue removed, the antibiotic did its work and his condition began to improve.
The Centers of Disease Control and Prevention says that 20,000 deaths in the US yeah year are linked to antibiotic-resistant MRSA infections.
“I just think people need to be aware that they can die from a gardening incident,” told Insider
“I personally had to demand a diagnostic test to be able to get treatment, the right treatment for my infection.”
And he urged patients to question their doctors about their condition.
“‘Why are you giving me this? Did you actually test for bacteria? Do you actually know what I have?’” He said.
Join our commenting forum
Join thought-provoking conversations, follow other Independent readers and see their replies
Comments

Bookmark popover
Removed from bookmarks